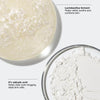

OFFER

-
DETAILS Advanced blemish-fighting formula Powerful topical blemish treatment with 2% salicylic acid helps visibly clear breakouts and prevent new ones by targeting pore-clogging oil and dead skin cells. Visibly soothes skin Helps visibly reduce redness caused by irritation. Two ways to use Use this lightweight gel all over your face to help prevent new blemishes from forming or as a spot treatment to quickly target an existing or emerging blemish. Invisible finish Dries quickly. Layers well with the rest of your skincare and makeup. HOW TO USE • Apply a thin layer to entire face twice a day after cleansing or apply as a spot treatment. Avoid eye area. • Using other topical blemish products at the same time or right after use of this product may increase dryness or irritation of skin. If this occurs, only one product should be used unless directed by a doctor. • Follow with a lightweight, oil-free moisturizer. • If bothersome dryness or peeling occurs, reduce usage to every other day. POWERFUL RESULTS Starts to visibly reduce the size of a blemish in just 1 hour.* Visibly reduces redness from irritation in just 2.5 hours.** *Clinical testing on 31 women after using product once. **After pre-treatment period; clinical testing on 25 women measured for 150 minutes, versus untreated control. KEY INGREDIENTS 2% salicylic acid Trusted blemish-fighting ingredient helps clear dead skin cells, oil, and other impurities that can contribute to clogged pores. Witch hazel Helps refine skin. Laminaria saccharina Helps break down oil that can clog pores and lead to breakouts. Lactobacillus ferment Helps visibly calm redness from irritation. Formula Facts: Clinical Expertise ; Dermatologist developed ; Dermatologist tested ; Allergy tested ; Fragrance free ; Non-comedogenic Free Of • Fragrance • Parabens • Phthalates • Oil • Gluten • Sodium lauryl sulfate • Sodium laureth sulfate • Synthetic colors
-
-
-
-
This product has a purchase limit of 0. If the limit is 0, there is no restriction on the quantity you can purchase.















